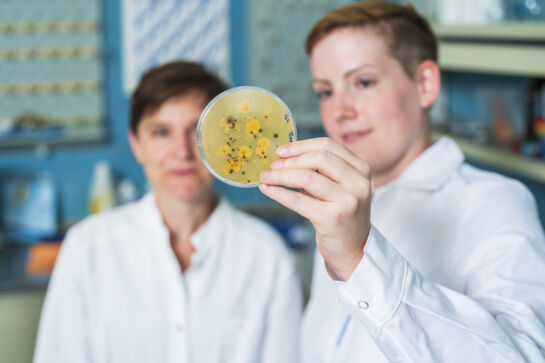

At Ensemo, we take the idea of seeding the future seriously. We believe that sustainable agriculture depends on the single seeds—and on the microbes that nature designed to support these seeds. Our aim, therefore, is to make these tiny living creatures our allies.
With our passion for microbial science and high-precision engineering, we are not just interested in innovation for innovation’s sake. Instead, we are driven by the conviction that biological seed treatment, when done right, can reduce the use of synthetic chemicals, strengthen crops from within, and restore balance between productivity and sustainability.